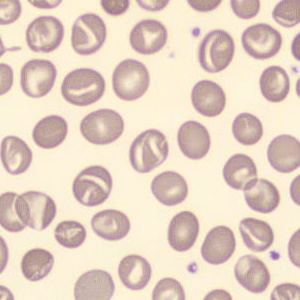

Upload
Haben Sie pädagogische Bilder von Blut oder Urin? Laden Sie sie über das Feld auf der rechten Seite hoch. Vielen Dank!
Urin
Gesucht
Newsletter
Abonnieren Sie den Newsletter, um über neue Entwicklungen informiert zu bleiben
Newsletter werden auf Englisch verschickt